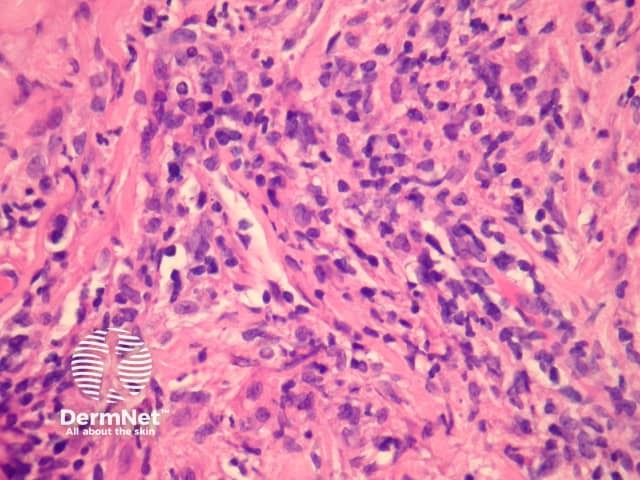
Figure 4

Main menu
Common skin conditions
NEWS
Join DermNet PRO
Read more
Quick links
Lesions (cancerous) Diagnosis and testing
Author: Assoc Prof Patrick Emanuel, Dermatopathologist, Auckland, New Zealand, 2013.
Introduction Histology Special studies Differential diagnoses
Extranodal NK/T cell lymphoma, nasal type, is an Epstein-Barr virus (EBV)-driven disease which typically primarily involves the upper respiratory tract (see Epstein–Barr virus-associated lymphoproliferative disorders). The skin is secondarily involved but a disease based primarily in the skin may also occur.
In extranodal NK/T cell lymphoma, nasal type, there is a dense dermal infiltrate (figure 1) which often extends into the subcutis. Exocytosis of atypical lymphocytes into the epidermis may be seen and may closely resemble mycosis fungoides (figure 2). The infiltrate in the dermis is usually polymorphous and may include numerous histiocytes and eosinophils. The atypical cells are small to medium sized with some larger forms (figures 3, 4). Commonly, the infiltrate infiltrates the walls of vessels (figures 3, 4) causing vascular nuclear debris (seen focally in figure 4). Necrosis is another common finding.

Figure 1

Figure 2

Figure 3
Figure 4
Special stains are essential for making the diagnosis. In-situ hybridization with EBV shows the atypical cells are positive. The atypical cells are generally positive with immunohistochemistry for CD56 and granzyme or TIA1. Some cases will express the T-cell marker CD3. T-cell gene rearrangement studies are usually negative.
Other peripheral T-cell lymphomas and subcutaneous panniculitis-like T-cell lymphoma can resemble this lymphoma. Positive T-cell gene rearrangement studies and positive T-cell immunohistochemical studies would favour a T-cell lymphoma. EBV, CD56 and granzyme expression are unusual findings in other T-cell lymphomas.